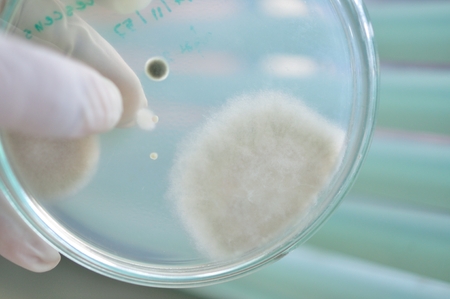
fungi in petridishの写真素材

写真素材 - fungi in petridish
キーワード
- agar
- antibiotic
- bacteria
- bacterial
- biology
- biotechnology
- blue
- chemical
- colony
- culture
- drug
- education
- experiment
- experimental
- fungi
- grow
- growth
- healthcare
- investigation
- lab
- laboratory
- macro
- medical
- medicine
- microbiology
- microorganisms
- molecular
- organism
- penicillin
- penicillum
- petri
- plate
- research
- science
- slant
- strain
- study
- test tube
- tube
- dish
- fungi
類似作品
fly agaric mush...
Dangerous poiso...
Gray Russula ve...
Close-up shot o...
close-up of mag...
Mysterious mush...
Close-up of mus...
Mushroom in the...
Amanita phalloi...
A mature fly ag...
Bracket fungus ...
Fragile not eat...
White mushroom ...
poisonous toads...
Mushroom wetwoo...
Honey mushrooms...
A group of mush...
Mysterious mush...
Mushrooms on th...
Snail shell emp...
Trametes versic...
Yellow hairy mu...
A mushroom sitt...
Mushroom growin...
Generative AI :...
Toadstool, clos...
Emerging from t...
Single mushroom...
Enchanting beau...
Close-up of vib...
Generative AI, ...
Mushroom in a w...
English woodlan...
A selective foc...
A cluster of ti...
Amanita poisono...
Parasol mushroo...
close-up of bio...
Mushrooms growi...
Mushroom growin...
Close-up of a w...
A macro shot of...
infected mushro...
Vibrant orange ...
A group of purp...
Mushrooms in an...
poisonous paras...
Earthy Mushroom...